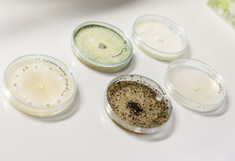
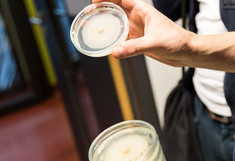

CAS Herbsttagung
15. BOKU CAS Herbsttagung: Adaptation to crises - Zukunft der Landwirtschaft in einer sich verändernden Welt
Die Landwirtschaft steht in einer Welt multipler Krisen – von aktuellen geopolitischen Spannungen über eine sich verschärfende globale Wettbewerbssituation, den Klimawandel bis hin zu ökonomischen und strukturellen Herausforderungen – vor tiefgreifenden Umbrüchen. Um die Ernährungssicherheit, Wettbewerbsfähigkeit und Nachhaltigkeit der Landwirtschaft in der EU und in Österreich auch in Zukunft zu gewährleisten, sind Anpassungen auf verschiedenen Ebenen erforderlich.
Die diesjährige Herbsttagung des BOKU Centre of Agricultural Sciences widmet sich der Frage, wie die derzeitigen Krisen auf den Agrarmarkt wirken, und wie Agrarpolitik und Landwirtschaft reagieren müssen, um in einer sich verändernden Welt zukunftsfähig zu bleiben. Im Fokus stehen die Rolle des EU-Außenhandels, notwendige poli- tische Antworten auf aktuelle Krisen, die Produktivität unter natürli- chen und strukturellen Bedingungen sowie das Spannungsfeld zwischen Effizienz und Resilienz landwirtschaftlicher Betriebe.
Ziel ist es, zentrale Handlungsfelder sichtbar zu machen und Impulse für die Weiterentwicklung von Strategien zu geben, die sowohl wirt- schaftliche Stabilität als auch ökologische und soziale Nachhaltigkeit berücksichtigen.
Das Programm zur Tagung finden Sie hier.
Zeit und Ort
Freitag, 21. November 2025 - 09:00 bis 15:00 Uhr
BOKU-Festsaal, Gregor-Mendel-Straße 33, 1180 Wien
YouTube Stream: https://youtube.com/live/S6_Cthh6UkI
Anmeldung
Die Tagung ist öffentlich und die Teilnahme ist kostenfrei, wir bitten aber um Anmeldung per mail an cas_anmeldungen(at)boku.ac.at
Wir freuen uns auf Ihr Kommen!
14. BOKU CAS Herbsttagung - Zukunftsfähige Agrar- und Ernährungssysteme – Beitrag der Nutztierwissenschaften
Die gegenwärtigen Agrar- und Ernährungssysteme erfüllen eine Vielzahl von Funktionen, stehen aber aufgrund ihres Beitrags zur Überschreitung der planetaren Grenzen vor erheblichen ökologischen, ökonomischen und sozialen Herausforderungen. Ihre zukunftsfähige Gestaltung erfordert eine grundlegende Transformation.
Den Nutztierwissenschaften kommt dabei vor dem Hintergrund der zunehmenden gesellschaftlichen Ansprüche hinsichtlich Tierwohl sowie klima-freundlichen und nachhaltigen Erzeugungsformen eine zentrale Rolle zu. Sie schaffen, idealerweise unter Einbeziehung nicht-wissenschaftlicher Akteur*innen, die Basis für nachhaltigkeitsorientierte Veränderungsprozesse.
Die diesjährige Herbsttagung des Zentrums für Agrarwissenschaften widmet sich daher dem Beitrag der BOKU-Nutztierwissenschaften zu zukunftsfähigen Agrar- und Ernährungssystemen. Ausgehend von einer systemorientierten Betrachtung der Rahmenbedingungen werden zentrale, praxisrelevante Forschungsthemen aus den Bereichen Tierzüchtung, Tierwohlwissenschaften und Tierernährung vorgestellt.
Das Programm zur Tagung finden Sie hier.
Zeit und Ort
Freitag, 6. Dezember 2024 - 09:00 bis 14:00 Uhr
Ilse-Wallentin-Haus, Seminarraum 29,
Peter-Jordan-Straße 82, 1190 Wien
YouTube Stream: https://www.youtube.com/live/EN6g_dRSfM8
Anmeldung
Die Tagung ist öffentlich und die Teilnahme ist kostenfrei, wir bitten aber um Anmeldung per mail an cas_anmeldungen(at)boku.ac.at
Wir freuen uns auf Ihr Kommen!
13. BOKU CAS HERBSTTAGUNG - Klimawandel und Wasser – Bedeutung für die österreichische Landwirtschaft
Die 13. CAS Herbsttagung fand am 01. Dezember 2023 am IFA-Tulln statt und widmete sich dem Thema Klimawandel und Wasser sowie dessen Bedeutung für die österreichische Landwirtschaft.
Im Rahmen der Herbsttagung waren sich Expert*innen einig: Die Verfügbarkeit von Wasser sowie nachhaltige, regenerative Bewirtschaftungsmethoden werden ausschlaggebend für zukünftige Ernteerträge sein.
Ausreichend Wasser ist Grundvoraussetzung für die landwirtschaftliche Produktion und damit ein entscheidender Faktor für die Ernährungssicherung. Die steigenden Temperaturen und die damit einhergehenden Änderungen bei Verdunstung, Niederschlägen und der Vegetationsperiode beeinflussen erheblich die Wasserverfügbarkeit. Die veränderten Niederschlagsmuster und -mengen sowie zunehmende Extremwetterereignisse bewirken Dürren und Überschwemmungen – auch in Österreich. Im Rahmen der 13. Herbsttagung an der Universität für Bodenkultur im IFA Tulln beleuchteten Forscher*innen, welche Auswirkungen Klimawandel und Wasser auf ihre Fachgebiete haben. Moderiert wurde die Tagung von Jochen Kantelhardt, dem Leiter des Zentrums.
Pflanzenanbau an Trockenstandorten
Hans-Peter Kaul vom Institut für Pflanzenbau an der BOKU widmete sich den Fragen, wie sich die Wasserverfügbarkeit im Boden steigern und wie sich die Wassernutzung der Nutzpflanzenbestände verbessern ließe und zog daraus Schlussfolgerungen, wie ein wassereffizientes Wirtschaften auf Trockenstandorten umsetzbar sei. „Wesentliche Ziele sind die kontinuierliche Bodenbedeckung, die Erhöhung des Humusgehaltes, die Verbesserung der Infiltration von Wasser in tiefere Bodenschichten sowie die Erhöhung des Anteils von Mittelporen mit pflanzenverfügbarem Wasser. Auf Seite der Pflanzen sind wassereffiziente Arten, insbesondere Pflanzen mit C4-Photosynthese sowie eine tiefe Durchwurzelung wichtig“, so Kaul. Der Anbau von Winterungen, auch bei traditionell im Frühjahr angebauten Kulturen und von frühreifen Sorten sei vorteilhaft. Die Bewässerung gewinne dabei zunehmend an Bedeutung, ebenso der Versicherungsschutz gegen Trockenschäden.
Modellstudien zur Verbesserung von Wasser- und Nährstoffverfügbarkeit
Bano Mehdi-Schulz vom Institut für Hydrologie und Wasserwirtschaft an der BOKU präsentierte in ihren ökohydrologische Modellstudien, welche Anpassungsmaßnahmen in Anbausystemen durch Bewirtschaftungsmaßnahmen möglich sind, um die Verfügbarkeit von Wasser und Nährstoffen in der Landschaft zu verbessern, um gute Erträge zu gewährleisten und das zukünftige Wassermanagement zu verbessern. „Bekannt ist, dass beispielsweise Winterbegrünung, konservierende Bodenbearbeitung und Mulchen dazu beitragen können, das nutzbare Wasser für das Pflanzenwachstum vor bzw. während der Vegetationsperiode zu erhöhen. Weniger erforscht ist jedoch, ob diese Maßnahmen auch unter Klimawandelszenarien wirksam sind und wie viel zusätzliches Bodenwasser gespeichert werden kann“, so Mehdi-Schulz. Ihre Modellierungsergebnisse zeigen jedoch auch, dass unter zukünftigen trockeneren Klimabedingungen die Erträge bei nachhaltigen Bewirtschaftungsmethoden höher sein können als bei konventioneller Bewirtschaftung.
Mikrobielles Leben in Böden
Gernot Bodner vom Institut für Pflanzenbau an der BOKU erörterte, warum Klimawandel-Anpassung und Klimaschutz im Ackerbau bei der Steuerung des mikrobiellen Lebens in den Böden beginnen. „Landwirtschaftliche Betriebe, die durch schonende Bodenbearbeitung und immergrüne Anbausysteme den Kleinstlebewesen in Böden einen möglichst naturnahen Lebensraum bieten, sind nicht nur im Humusaufbau erfolgreich, sondern schaffen auch resiliente Böden, die Trockenheit und Starkregen besser widerstehen können“, so Bodner. Bodengesundheit durch regenerierende Landwirtschaft als Weg zu einem klimafitten Ackerbau finde nicht nur in Pionierbetrieben, sondern auch in der Praxis zunehmend Anklang. „Innovationen in der Bodennutzung sind auch wesentlicher Bestandteil, um die Klima- und Bodenschutzziele im Rahmen des Green Deals zu erreichen.“ Umso wichtiger sei die Integration von moderner Forschung und innovativer Praxis in Leuchtturmbetrieben, um das Verständnis komplexer biologischer Prozesse mit effektiven Managementlösungen zu verbinden – und die Erfolge zu demonstrieren.
Klimawandel und Weinbau
Astrid Forneck vom Institut für Wein- und Obstbau an der BOKU gab einen Forschungseinblick zu Fragen und Projekten, die sich mit Effekten von Trockenheit und Hitze auf die Traubenqualität und Rebenvitalität im Weinbau beschäftigen. „Die Weinrebe ist als mehrjährige Kultur besonders vom Klimawandel betroffen“, so Forneck. Die hohen Temperaturen in der verfrühten Reifephase habe starke Effekte auf die Traubenqualität und Rebsortentypizität von Rebsorten wie Grüner Veltliner und Blaufränkisch. „Der effiziente Umgang mit Wasser bei Trockenheit im Weingarten erfordert neben innovativer Produktionstechnologie auch Wissen über die Anpassung österreichscher Rebsorten an eine reduzierte Wasserverfügbarkeit.“ Erste Forschungsprojekte zeigen, dass sich die Weinrebe - erstmals untersucht an Grünem Veltliner - an Trockenstress anpassen kann. „Unser Ziel ist, die Strategien dieser Rebe, die ihre Wassernutzungseffizienz steigert, um die Traubenqualität zu erhalten, zu erforschen. Das Ergebnis dieser Grundlagenforschung soll zukünftig helfen, den Wasserverbrauch der Rebe zu steuern.
Zukünftige Änderungen der Bodenwasserbilanz in Österreich
Untersuchungen am Institut für Bodenphysik und landeskulturelle Wasserwirtschaft an der BOKU zeigen klar auf, dass es erhebliche Unterschiede in der Wasserverfügbarkeit zwischen dem Westen und dem Osten Österreichs gibt. „Die Daten aus dem Langzeit-Monitoring ermöglichen uns, Wasserflüsse sowie den Bodenwasserstatus zu berechnen. Sie zeigen eine höhere Wasserverfügbarkeit im Westen des Landes im Vergleich zum Osten“, so Christine Stumpp. „Allerdings lassen sich die Mengen an Verdunstung und Grundwasserneubildung für die Zukunft nur schwer vorhersagen, weil sich große Unterschiede je nach Klimaszenario ergeben.“ Die Erkenntnisse tragen dazu bei, das Verständnis für die ökologischen Unterschiede innerhalb Österreichs zu vertiefen, die Bewässerung im Osten und Südosten Österreichs werde an Wichtigkeit zunehmen, längere Trockenperioden sowie Starkniederschlagsereignisse die Gefahr von Bodenerosion erhöhen.
Besondere Herausforderungen in der Emilia-Romagna
Davide Viaggi vom Department of Agricultural and Food Sciences an der Universität Bologna erörterte die Herausforderungen der zunehmenden Klimaschwankungen für die Landwirtschaft am Beispiel der Emilia-Romagna im Zeitraum 2022-2023. Dieses Gebiet ist historisch durch eine starke Umwandlung der Landschaft und natürlichen Umgebungen durch menschliches Handeln wie Landgewinnung, Entwicklung von Wasserinfrastrukturen und politische Maßnahmen mit Schwerpunkt auf Wassereinsparung und Dürremanagement gekennzeichnet. „Die Überschwemmungen im Jahr 2023 und deren Auswirkungen wie auf Flachland und Berggebiete - wie Erdrutsche - erfordern sowohl kurzfristige Maßnahmen als auch längerfristige Überlegungen zu einer Politik, die besser auf Klimaschwankungen reagiert und eine bessere Koordinierung zwischen den Hauptakteuren gewährleistet.“
Das Programm zur Tagung finden Sie hier.
Die Videoaufzeichnung der Tagung finden Sie unter folgendem Link:
https://youtube.com/live/OePN3zlRukI
12. BOKU CAS Herbsttagung // Ernährungssicherheit in einer unsicheren Zeit – Globale Perspektiven und Spotlights aus der Züchtung
Ernährungssicherheit in einer unsicheren Zeit – Globale Perspektiven und Spotlights aus der Züchtung
Die 12. CAS Herbsttagung fand am 18. November 2022 an der BOKU statt und widmete sich dem Thema der Ernährungssicherung und bot ein Forum, auf dem globale Perspektiven vor allem der Beitrag der Züchtung zur Erreichung nachhaltiger Ernährungssicherheit in der Zukunft diskutiert wurde
Im Einführungsvortrag sprach Stefan Schmitz (Executive Director, Crop Trust, Bonn) über die Bedeutung der Nutzpflanzenvielfalt im Kontext der Ernährungssicherheit. Sein Vortrag stellte insbesondere die Wichtigkeit von Saatgutbanken heraus, in denen pflanzengenetische Vielfalt dauerhaft bewahrt wird. „Es ist wichtig Saatgutbanken zu erhalten, zu modernisieren
und für künftige Forschung verfügbar zu machen. Die Entwicklung landwirtschaftlicher Erträge im Klimawandel wird in sehr vielen Räumen der Erde rückläufig sein, damit wird die Bedeutung von Pflanzenzüchtung auf der Basis von Vielfalt deutlich wichtiger werden“, so Schmitz.
Karlheinz Erb, (SEC, BOKU), machte in seinem Vortrag deutlich, dass das globale Ernährungssystem einer der maßgeblichsten Treiber für eine nachhaltige Entwicklung, für den „globalen Wandel“ darstellt. Eine besondere Rolle spielt hierbei die Erzeugung und der Konsum tierischer Nahrungsmittel. Ernährungsumstellungen, die zu einer Verminderung des Konsums tierischer Produkte führen, haben vielfältige positive Effekte auf die Nachhaltigkeit wie z. B. verringerter Flächendruck, Schaffung von Kohlenstoffsenken, verringerte Intensität der Landnutzung, reduzierter Druck auf die Biodiversität. Dabei darf die Verantwortung aber nicht nur auf die Konsument*innen übertragen werden, vielmehr braucht es strukturelle Strategien in der Futtermit
tel- und der tierischen Produktion.“
Johann Vollmann (Institut für Pflanzenzüchtung, BOKU) ging in seinem Vortrag darauf ein, welchen Beitrag die Sojabohnenzüchtung zur Ernährungssicherheit leisten kann. Das größte Potenzial sieht er hierbei in der Zucht von Sorten mit entsprechenden Proteinqualitäten und rträgen. Er hob auch hervor, dass die Sojabohne, die weltweit vor allem als Futtermittel eingesetzt wird, auch großes Potential für die menschliche Ernährung hat, unter der Voraussetzung, dass eine ausreichende Diversität als Basis erfolgreicher Zucht vorhanden ist. „Wenn wir eine Ernährungswende und mehr pflanzliches Protein direkt in unserer Ernährung einsetzen wollen, brauchen wir genetische Diversität. Wir brauchen diese Diversität auch zur Gewährung von Lebensmittelsicherheit, wobei Themen wie z. B. Allergene, Schwermetalle oder Gesundheitseffekte schlagend werden können“ so Vollmann.
„Tiergenetische Ressourcen können eine wichtige Rolle für die Erreichung der Sustainable Development Goals, die Ernährungssicherheit, die Armutsbekämpfung, das Wirtschaftswachstum und eine gesteigerte Resilienz spielen“, betonte Roswitha Baumung (Animal Production Officer, FAO). Es müssen standortangepasste Arten und Rassen eingesetzt werden, was nur möglich ist, wenn auf eine gewisse Rassenvielfalt zurückgegriffen werden kann. In der Zucht ist es essentiell, verstärkt auf Zuchtmerkmale zu setzen, welche die Anpassungsfähigkeit, Robustheit und Resilienz verbessern. Im Zuge der verstärkten Kritik an der Nutztierhaltung, hob Baumung zudem hervor, dass weltweit 6 Mrd. Tonnen an Futtermitteln in der Nutztierhaltung eingesetzt werden, wovon der Großteil nicht direkt für die menschliche Ernährung verwendet werden kann. Nutztiere können diese Futtermittel aber zu hochwertigen Nahrungsmittel veredeln.
In der österreichischen Rinderzucht konnten bei der Milch- und Lebensleistung enorme Entwicklungen erreicht werden. Gleichzeitig wurde in den letzten Jahr(zehnt)en aber auch ein klarer Fokus auf die Verbesserung im Bereich funktionaler Merkmale gelegt (z. B. Gesundheitsmerkmale). „Diese balancierten Zuchtziele in Österreich sehe ich als eine Entwicklung an, die insgesamt
in die richtige Richtung geht, insbesondere was die Fitnessmerkmale betrifft. Eine konsequente Datenerhebung und -nutzung, eine moderne Zuchtwertschätzung, sowie die Offenheit gegenüber Wissenschaft und Innovationen tragen wesentlich zum züchterischen Erfolg bei“, machte Birgit Fürst-Waltl (NUWI, BOKU) deutlich.
Stefanie Lemke (IDR, BOKU) betonte im letzten Vortrag, dass es für eine nachhaltige Ernährungssicherheit einer grundlegenden Transformation der Ernährungssysteme bedarf. Hierfür müssen vor allem die strukturellen Ursachen von Benachteiligung erforscht und verändert werden: „Wir brauchen Geschlechtergerechtigkeit und Teilhabe im Sinne von wahrhaftiger Beteiligung, wie z.B. die Teilhabe an Land, Bildung und Gesundheit, besonders für bestimmte Gruppen von Frauen und Jugendlichen, im Sinne eines intersektionalen Ansatzes, der verschiedene Kategorien sozialer Ungleichheit in den Blick nimmt. Das ist wichtig nicht nur im Süden, sondern im globalen Kontext. Das Recht auf angemessene Nahrung und Ernährungssouveränität muss stärker in den Blick genommen werden.“
Die Tagung fand dieses Jahr wieder analog an der Türkenschanze statt, das Programm zur Tagung finden Sie hier.
Die Videoaufzeichnung der Tagung finden Sie unter folgendem Link:
www.youtube.com/watch?v=xzs4u3qlQE0
11. BOKU CAS Herbsttagung // From Farm to Fork - Konsequenzen für die österreichischen Landwirtschaft
Am Freitag, den 12. November 2021, fand die 11. Herbsttagung des Zentrums für Agrarwissenschaften der Universität für Bodenkultur statt.
Die Konferenz stand im Zeichen der europäischen "Farm-to-fork" Strategie, wobei insbesondere das Ziel der "Sicherstellung einer nachhaltigen Lebensmittelproduktion" behandelt wurde.
Die "Farm to Fork"-Strategie (F2F) der Europäischen Kommission soll den Übergang zu einem fairen, gesunden und umweltfreundlichen Lebensmittelsystem in Europa vorantreiben. Dafür werden für jede Stufe der Lebensmittelwertschöpfungskette Ziele vorgeschlagen, die von den EU-Mitgliedsstaaten über nationale Umsetzungsstrategien erreicht werden sollen.
Die Ziele der F2F, die direkt die landwirtschaftliche Produktion betreffen, sind ambitioniert: So sollen deutliche Einschränkungen im Einsatz von Pestiziden, Düngemitteln und Antibiotika umgesetzt und ein großer Anteil der landwirtschaftlichen Flächenbewirtschaftung in Europa auf biologische Wirtschaftsweise umgestellt werden – alle Ziele sollen bereits innerhalb der nächsten Jahre erreicht werden.
Vor diesem Hintergrund behandelte die Herbsttagung 2021 des BOKU Zentrums für Agrarwissenschaften die 4 quantitativen Ziele der F2F im Bereich „Sustainable food production“, nämlich die der Inputreduktionen und der Ausweitung der biologischen Landwirtschaft, als zentrales Thema.
-
die Reduktion des Gesamtverbrauchs, des Risikos und des Einsatzes von gefährlichen Pestiziden um 50%
-
die Reduktion der Nährstoffverluste um mindestens 50 % und die Reduktion des Düngereinsatzes um 20%
-
die Reduktion des Verkaufs von antimikrobieller Mittel für die Tierhaltung und in der Aquakultur um 50%
-
die Erreichung eines Anteils von mindestens 25% der landwirtschaftlichen Fläche der EU, die biologisch bewirtschaftet wird
Es ist offensichtlich, dass die Ziele der F2F Strategie den Anspruch an eine nachhaltigere Ressourcennutzung und Inputstrategie durch die Landwirtschaft erhöhen, und Auswirkungen auf die landwirtschaftliche Produktivität haben werden. Im Mittelpunkt der diesjährigen Herbsttagung des Zentrums für Agrarwissenschaften (CAS) der Universität für Bodenkultur Wien stand deshalb die wissenschaftliche Analyse, der vier quantitativen Ziele der F2F und die Diskussion der Potentiale, aber auch der Grenzen einer Umsetzung für die österreichische Landwirtschaft. „Es steht außer Frage, dass die Umsetzung der F2F-Strategie auch die österreichische Landwirtschaft vor große Herausforderungen stellt. Dabei sollte nicht nur die kurzfristige Umsetzbarkeit und die kurzfristigen Konsequenzen der Strategie bewertet, sondern auch die langfristigen Entwicklungspotentiale einer solchen Politik betrachten werden“, so Jochen Kantelhardt, Leiter des BOKU CAS.
Der für Landwirtschaft und ländliche Entwicklung zuständige Generaldirektor der Europäischen Kommission, Wolfgang Burtscher, unterstrich die veränderte Ausrichtung der Gemeinsamen Agrarpolitik (GAP): „Die GAP ist ein wichtiges Instrument, um die Nachhaltigkeit unserer Lebensmittelsysteme zu erreichen.“ Mit der F2F-Strategie müsse die Lebensmittelproduktion und das landwirtschaftliche Einkommen mit echten Verbesserungen für die Umwelt und die öffentliche Gesundheit einhergehen. „Aus diesem Grund wird die Europäische Kommission den Ambitionen der neuen strategischen Pläne der Mitgliedstaaten für die GAP große Aufmerksamkeit schenken“, so Burtscher.
Notwendigkeit, Möglichkeit und Realität bei der Minimierung von Pestiziden
„Pflanzenkrankheiten, Schädlinge und Beikräuter sind keine Folge der heutigen Landwirtschaft, sondern begleiten den Menschen, seit es Ackerbau gibt“, betonte Siegrid Steinkellner vom Institut für Pflanzenschutz an der BOKU. „Pflanzenschutzmaßnahmen tragen entscheidend zur Sicherung der Erträge und der Qualität von Lebens- und Futtermitteln sowie nachwachsenden Rohstoffen für die industrielle Verwertung bei. Die bis 2030 gesetzten Ziele zur Pestizidreduktion folgen einem gesellschaftlichen Meinungstrend, überschätzen jedoch die Möglichkeiten und negieren viele reale Pflanzenschutzprobleme.“
Reduktion von Nährstoffverlusten und Düngemittelaufwand
Jakob Santner vom Institut für Pflanzenbau an der BOKU beleuchtete die Herausforderungen, die die F2F-Strategie an die österreichische Landwirtschaft in Bezug auf die Reduktion von Nährstoffverlusten und Düngemitteleinsatz stellt. „Da die Nährstoffeffizienz von Stickstoff und Phosphor in Österreich aktuell schon sehr hoch ist, sind weitere Effizienzsteigerungen nicht einfach zu erreichen.“ Um weiterhin hohe Flächenerträge bei geringerem Düngemittelaufwand zu realisieren, seien die Weiterentwicklung der eingesetzten Düngemittel (z.B. slow-release Produkte, Düngemittelplatzierung) und auch die Entwicklung von Kultursorten mit höherer Nährstoffaufnahme- und Nährstoffausnutzungseffizienz vielversprechend. „Auch die Nährstoffrückgewinnung aus Reststoffen und der Einsatz in Regionen mit hohem mineralischen Düngemittelbedarf könnten, wenn wirtschaftliche Rückgewinnungstechnologien verfügbar werden, einen Beitrag zur Effizienzsteigerung leisten.“
Reduktion von antimikrobiellen Mitteln in der Veterinärmedizin
Mit der neuen EU-Tierarzneimittel-Verordnung wurden Rahmenbedingungen geschaffen, die u.a. auf eine verbesserte Erhebung von Verkaufs- und Anwendungsdaten für Antibiotika abzielen und den vorsichtigen Einsatz von Antibiotika fördern. Auch Österreich ist gefordert, die Verbreitung von Antibiotikaresistenzen zu reduzieren. „Bei der Reduktion des Antibiotikaeinsatzes ist eine reine Mengenbetrachtung nicht zielführend, vielmehr muss die Anzahl der behandelten Tiere reduziert werden“, so Annemarie Käsbohrer von der Abteilung für Öffentliches Veterinärwesen und Epidemiologie an der Vetmeduni. Auch ein alleiniges Ausweichen auf kritische Wirkstoffgruppen mit geringerer Dosierung wäre ein fataler Schritt. „Antibiotika dürfen nicht dazu missbraucht werden, unzureichende Haltungsbedingungen, Managementfehler oder mangelhafte Hygienestandards zu kompensieren.“
Wachstum des Biolandbaus mit Augenmaß
Die biologische Landwirtschaft in der EU ist inzwischen ein etablierter Teil der Landwirtschaft, der sich durch eine starke Umwelt und Tierwohl-Orientierung auszeichnet und bei Verbrauchern Ansehen genießt. „Das Ziel der EU-Kommission, den Bio-Sektor bis 2030 auf 25% ausbauen zu wollen, enthält jedoch eine Reihe von Herausforderungen“, betont Sebastian Lakner von der Agrar- und Umweltwissenschaftlichen Fakultät der Universität Rostock. Bisher hätten Marktprozesse auf dem deutschen Biomarkt funktioniert, weil die biologische Landwirtschaft immer mit Blick auf den Markt gewachsen ist. Das Resultat waren stabile Preise. „Wenn die Subventionen zu stark angehoben werden, könnten Erzeugerpreise sinken und Betriebe ihre Kosten nicht decken und müssten über eine Rückumstellung nachdenken.“ Insofern sei agrarpolitisches Augenmaß gefragt. „Mittelfristig sollten wir eine Diskussion darüber führen, wie der Biolandbau das eigene Profil im Hinblick auf Umweltleistungen, Produktivität, Innovation und multifunktionale Leistungen schärfen - und wie auch die konventionelle Landwirtschaft ihre Bilanz im Hinblick auf Umweltleistungen, Tierwohl und Qualität verbessern kann“, so der Agrarökonom.
Die Tagung fand auch dieses Jahr online statt, das Programm zur Tagung finden Sie hier.
Präsentationen zum Download:
Minimierung des Pestizideinsatzes: Notwendigkeiten - Möglichkeiten - Realität
Univ.Prof. Dipl.-Ing. Dr.nat.techn. Siegrid Steinkellner
Institut für Pflanzenschutz, Universität für Bodenkultur Wien
Das 25%-Ökolandbau Ziel: Chancen und Risiken einer EU-weiten Ausbaustrategie
Univ.Prof. Dr. Sebastian Lakner
Agrar-und Umweltwissenschaftliche Fakultät, Universität Rostock
10. BOKU-CAS Herbsttagung - Digitalisierung in der Landwirtschaft
-

(C) DILAAG
Die Digitalisierung in der Landwirtschaft gewinnt immer stärker an Bedeutung, sowohl für die regionale wirtschaftliche Entwicklung und den Umweltschutz, als auch für die Welternährung und den Klimawandel. Durch neue Technologien können knapper werdende Ressourcen effizienter genutzt, die Ertragssicherheit der landwirtschaftlichen Produktion erhöht und der Einsatz von Pestiziden und Düngern reduziert werden.
Die gemeinsame Tagung des Projektes „DiLaAg – Digitalisierungs- und Innovationslabor in den Agrarwissenschaften“ (DiLaAg), des BOKU Zentrums für Agrarwissenschaften (BOKU CAS) und der BOKU-Standortinitiative für Bio-Resources & Technologies Tulln (BiRT) gab einen Einblick in den Stand des Wissens und aktuelle Forschungsprojekte zum Thema Digitalisierung in der Landwirtschaft.
Diskutiert wurden – in diesem Jahr online – unterschiedliche digitale Technologien wie Sensorik, Robotik, Automation, Big Data, Internet der Dinge und Künstliche Intelligenz. Im PhD-Programm „DiLaAg – Digitalisierungs- und Innovationslabor in den Agrarwissenschaften“ haben sich die BOKU, die TU Wien und die Veterinärmedizinische Universität Wien 2019 zusammengeschlossen, um gemeinsam den wissenschaftlichen Nachwuchs auszubilden und eine Plattform für Forschung und Beratung zu gründen. Derzeit nehmen acht Dissertant*innen an dem PhD-Programm teil, die im Rahmen der Tagung ihre Forschungsarbeiten präsentierten. Gefördert wird das Projekt durch die Forum Morgen Privatstiftung sowie das Land Niederösterreich.
Im Fokus von DiLaAg stehe, die Kompetenzen der drei Universitäten zu vernetzen und neue Technologien in der Praxis anwendbar zu machen, erläuterte Univ.-Prof. Dr. Andreas Gronauer, Vorstand des Instituts für Landtechnik der BOKU. Einen weiteren Schwerpunkt bildet die Innovationsplattform „Digital Agricultural Lab“, wo die Vernetzung mit Praxisbetrieben sowie ein Firmennetzwerk fördernder Unternehmen aufgebaut wird.
Digitalisierung auch für kleine Betriebe ermöglichen
Digitalisierung wird einen so technikorientierten Bereich wie die Landwirtschaft in Zukunft stark prägen. „Es zeigt sich, dass die Digitalisierung umfangreiches Potential bietet, die Produktivität der Landwirtschaft weiter zu erhöhen und mit den neuen Möglichkeiten einer abgestuften und ressourcenschonenden Flächennutzung auch umfangreiche Chancen für den Natur- und Umweltschutz schafft“, so Prof. Dr. Jochen Kantelhardt, Leiter des BOKU Zentrums für Agrarwissenschaften. Zu beachten sei allerdings, dass die Digitalisierung so umgesetzt werden müsse, dass auch kleinere Betriebe die Möglichkeiten bekommen, an dieser Entwicklung teilzuhaben.
Landwirtschaft digitale Vorreiterin
„Die Landwirtschaft ist bei der Digitalisierung bereits seit den 1990er-Jahren Vorreiterin“, führte Prof. Dr. Engel Friederike Hessel, Unterabteilungsleiterin und Digitalisierungsbeauftragte im Deutschen Bundesministerium für Ernährung und Landwirtschaft (BMEL) in ihrer Keynote. Ziel des Bundesministeriums sei, nachhaltige Digitalisierung zu begleiten und zu fördern. Zu diesem Zweck wurde im Ministerium vor zwei Jahren die Unterabteilung „Digitale Innovation“ ins Leben gerufen, das BMEL fördert die digitale Transformation in den kommenden drei Jahren mit 50 Mio. Euro.
Anwendungsgebiete der Digitalisierung seien unter anderem der effiziente Einsatz von Ressourcen, beim Tierwohl, bei der Verwendung von Dünger und Pflanzenschutzmittel. „Digitalisierung fördert aber auch die Transparenz in der Lebensmittelkette“, so Hessel. Weitere Ziele des BMEL sind der Ausbau digitalen Infrastruktur im ländlichen Raum und die Vernetzungsmöglichkeit von Daten. Denn, wie Hessel betonte, „maschinenlesbare Daten sind der Schlüssel zur Digitalisierung in der Landwirtschaft“.
Austausch zwischen Wissenschaft und Gesellschaft
Für die innovative Nutzung der Digitalisierung im Bereich der Landwirtschaft (Smart Farming) müssten die hierzu notwendigen Kompetenzen und Fähigkeiten sowohl in den Bereichen von Forschung und Lehre als auch in denen der Aus-und Weiterbildung viel intensiver und reflektierter vermittelt werden als es bis dato der Fall ist, lautete das Resümee von Prof. Dr. Eberhart Hartung, Präsident des deutschen Kuratoriums für Technik und Bauwesen in der Landwirtschaft (KTBL) in seiner Keynote „Smart farming technologies – Herausforderungen für Forschung und Lehre“. Um die Potentiale der Digitalisierung im Bereich der Landwirtschaft und dem nachhaltigen Erhalt und der Förderung des ländlichen Raums ausschöpfen zu können, wären die essentiellen Bedarfe an einer international abgestimmten Dateninfrastruktur und der Bereitstellung von belastbaren „Gold-Standards“ für optimale Sensor-/Informationsnutzung zu schaffen sowie Strategien zur Förderung der IT-Kompetenz umzusetzen, so Hartung.
Sensortechnologie für Tierwohl
Ein wesentlicher Bestandteil des Precision Livestock Farming ist der Einsatz moderner Sensortechnologie. Prof. Dr. Marc Drillich vom Department für Nutztiermedizin und öffentliches Gesundheitswesen der Veterinärmedizinischen Universität Wien referierte zum Thema „Einsatz von Beschleunigungssensoren zum Monitoring von Milchkühen“. Beschleunigungssensoren am Tier liefern Bewegungsprofile, die durch den Einsatz von Algorithmen und Künstlicher Intelligenz die Erkennung bestimmter physiologischer oder pathologischer Zustände ermöglichen. „Das automatisierte Tiermonitoring liefert Daten und Informationen, die für die Überwachung der Tiergesundheit und des Tierwohls in Zukunft eine zentrale Rolle spielen werden“, lautete Drillichs Einschätzung des Potentials digitaler Technologien in der Nutztierhaltung.
Reproduzierbarkeit von komplexen Analyseprozessen
Prof. Dr. Andreas Rauber vom Institute of Information Systems Engineering der TU Wien erläuterte, warum der Reproduzierbarkeit von Ergebnissen eine essentielle Bedingung in Analyseprozessen zukommt, um Entscheidungen nachvollziehen, begründen und ihnen vertrauen zu können. „Obwohl dies eine triviale Anforderung zu sein scheint, zeigen sich in der Praxis zahlreiche Herausforderungen“, so Raumer, der im Rahmen seines Vortrags Beispiele aufzeigte und Lösungsansätze vorstellte, wie auch komplexe Analyseprozesse, welche mit sich laufend ändernden Daten operieren, zuverlässig und reproduzierbar durchgeführt werden können.
Vom Sensor zum Smart Farming
Durch die vermehrte Einbindung der Methoden der Informatik verändern sich die Arbeitsabläufe und Prozesse in der Landtechnik, aber auch die verwendete Technik selbst. Die Entwicklung und Einbindung von Sensorik, die nicht mehr nur zur Steuerung und Regelung der verwendeten Landmaschinen genutzt wird, sondern zur Abbildung der verschiedensten Parameter des ganzen Sytems (Boden, Pflanze, Maschine, Mensch, Umwelt, etc.) stellt oftmals den ersten Schritt im Smart Farming der Zukunft dar, wie Dr. Viktoria Motsch vom Institut für Landtechnik der BOKU in ihrem Beitrag „Data-Driven Agriculture: Status quo und zukünftige Herausforderungen im Smart Farming“ ausführte. So verfügen moderne Geräte über satellitengesteuerte Navigations- und Kartierungssysteme, die eine zielgerichtete Mengenausbringung erlauben (Precision Farming). Motsch: „Nur durch diese Weiterentwicklung und ein gutes Zusammenspiel dieser unterschiedlichen Ansätze kann sich der Kreis vom Sensor bis zur Nutzung der generierten Information schließen.“
Die Tagung fand am 22. Oktober 2020, von 9:00 bis 16:00 Uhr online statt.
Das Programm zur Tagung finden Sie hier
Vorträge
Begrüßung: Rektor Prof. Dr. DDr. h.c. Hubert Hasenauer
Digitalisierung in der Landwirtschaft - Umsetzungsstrategie des BMEL
Prof. Dr. Engel Friederike Hessel, Unterabteilungsleiterin und Digitalisierungsbeauftragte im Deutschen Bundesministerium für Ernährung und Landwirtschaft
Smart farming technologies – Herausforderungen für Forschung und Lehre
Prof. Dr. Eberhard Hartung, Präsident des deutschen Kuratoriums für Technik und Bauwesen in der Landwirtschaft (KTBL)
Das Digitalisierungs- und Innovationslabor in den Agrarwissenschaften
Prof. Dr. Andreas Gronauer, Institut für Landtechnik, Universität für Bodenkultur Wien
Doktoratsvorträge
Georg Supper: Datenbasierte, vernetzte Prozessführung in der Agrartechnik
Florian Kitzler: Integration von Bestandsparametern für intelligente landwirtschaftliche Prozesse
Lukas Koppensteiner: Strategische Sammlung und Bereitstellung von Feldversuchsdaten
Barbara Pichlbauer: Sensor-basiertes Monitoring der Weidehaltung von Milchkühen
Sebastian Raubitzek: Machine Learning and Chaos Theory for Data Analysis in Agriculture
Kannan Peesapati: Explainable Artificial Intelligence and its role in smart agriculture
Warren Purcell: Data resilience in agriculture
Francisco Medel: Life cycle assessment and economic evaluation of variable rate nitrogen application using a ground-based optical plant sensor
Einsatz von Beschleunigungssensoren zum Monitoring von Milchkühen
Prof. Dr. Marc Drillich, Veterinärmedizinische Uni Wien
Reproduzierbarkeit im Bereich der Datenanalyse: Herausforderungen und Lösungen
Prof. Dr. Andreas Rauber, Institute of Information Systems Engineering, TU Wien
Data-Driven Agriculture: Status quo und zukünftige Herausforderungen im Smart Farming
Dr. Viktoria Motsch, Institut für Landtechnik, Universität für Bodenkultur Wien
Die Tagung wurde am Vorabend, 21.10.2020 mit einer Live-Stream Podiumsdiskussion zum Thema Digitalisierung in der Landwirtschaft mit Vertretern aus der Politik, Wissenschaft und Praxis eingeleitet. Den Link zur Podiumsdiskussion finden Sie hier.
Anmeldung
9. BOKU CAS Herbsttagung: LANDNUTZUNG - Globale Herausforderungen und regionale Perspektiven
Wald, Acker, Siedlung oder Shoppingcenter: Landnutzung unter Konkurrenzdruck
Die Herbsttagung 2019 des BOKU-Zentrums für Agrarwissenschaften widmete sich dem komplexen Thema der Landnutzung.
Drei Viertel der globalen Landfläche wird vom Menschen genutzt. Das Bevölkerungswachstum, und die ressourcenintensiven Konsumweisen der Industrie-, und zunehmend auch der Schwellenländer, verstärken den Druck auf die Flächennutzung und verschärfen die Konkurrenz zwischen den unterschiedlichen Landnutzungsformen wie Land- und Forstwirtschaft, Siedlungsbau, Verkehr und Infrastruktur, und der Landnutzung zur Gewinnung von Industrieressourcen.
Die Landnutzung verändert die globalen Ökosysteme, und gefährdet vermehrt deren Fähigkeit, sogenannte „Ökosystemleistungen“ bereitzustellen. Beispiele für (gefährdete) Ökosystemleistungen sind die Bestäubungsleistung von Insekten, die dafür verantwortlich ist, dass rund ein Drittel unserer Nahrungsmittelpflanzen wachsen können, oder die Fähigkeit von Böden, Kohlenstoff zu speichern und so dem Klimawandel entgegenzuwirken.
Die Herbsttagung 2019 des BOKU Zentrums für Agrarwissenschaften widmete sich dem komplexen Thema Landnutzung, indem sie globalen Herausforderungen diskutierte und regionale Perspektiven aufzeigte.
Intensive Nutzung mit Folgen
„Die aktuelle Landnutzung ist vielfach kritisch zu bewerten“, betonte Jochen Kantelhardt, Leiter des CAS (Centre of Agricultural Sciences) an der Universität für Bodenkultur Wien, in seiner Eröffnungsrede. „Die Ausweitung und Intensivierung der Flächennutzung wirken sich oft negativ auf die Funktionsfähigkeit natürlicher Ökosysteme aus.“ Allerdings muss die Landnutzung vielfältigen Ansprüchen gerecht werden. „Es bestehen unterschiedliche Interessen, wie die Ernährung der Weltbevölkerung, der Naturschutz, oder die Bereitstellung von Ressourcen, die zu Konkurrenzen führen, wie beispielsweise der Verlust und die Verbauung landwirtschaftlicher Flächen. Eine Balance zu finden ist eine große und komplexe Aufgabe.“
Wechselwirkungen erkennen und verstehen
Die Sicherung der Welternährung im Jahr 2050 steht vor großen Herausforderungen: Einerseits wird der Klimawandel die Landnutzung stark verändern. Andererseits soll die Landnutzung beim Klimaschutz helfen, indem Bioenergie-Pflanzen gepflanzt werden. Helmut Haberl vom Institut für Soziale Ökologie an der BOKU macht klar: „Wer erwartet, dass Bioenergie-Pflanzen künftig stärker zur globalen Energieversorgung beitragen, muss wissen, dass diese Flächen nicht mehr für Nahrungsmittel zur Verfügung stehen. Die Konkurrenz um fruchtbares Land wird somit steigen“. Landkonkurrenz hängt auch von den zukünftigen Ernährungsmustern ab: „Steigt der tierische Anteil an der Ernährung, so vergrößert sich der Flächenbedarf. Zwar kann man den Flächenbedarf durch Intensivierung eingrenzen, durch den höheren Bedarf an Düngemitteln kommt es jedoch zu einem anderen Problem: die Störung des globalen Stickstoff-Haushaltes"
Selbst Klimaschutzmaßnahmen wie die Aufforstung von Wäldern haben Wechselwirkungen, die infrage stellen, ob die Verbrennung von Biomasse wirklich CO2-neutral ist: „Aktuelle Forschungsarbeiten zeigen, dass die Treibhausgas-Emissionen aus Bioenergie mit zunehmender Bioenergieproduktion ansteigen. In vielen Fällen würde eine Renaturierung genutzter Flächen in den kommenden Jahrzehnten mehr CO2 binden, als durch Bioenergienutzung auf diesen Flächen an Fossilenergie eingespart werden kann“, so Haberl.
Nachhaltige Raumentwicklung
Österreich wächst, sowohl was die Bevölkerung, als auch die Wirtschaft anlangt. Das Wachstum konzentriert sich vor allem in und um die Zentren, während inneralpine und periphere Regionen stagnieren oder schrumpfen. In vielen Ortschaften ist ein sogenannter „Donut-Effekt“ zu beobachten: Die Entwicklung findet am Ortsrand statt, land- und forstwirtschaftlichen Flächen müssen für Bauland und Infrastruktur weichen, während die Ortskerne an Bevölkerung, Betrieben und damit an Lebendigkeit verlieren. Der Verlust von Biodiversität und die Emission von Treibhausgasen sind die Folge. „Es wäre dringend notwendig, Raumentwicklung konsequent und nachhaltig umzusetzen, um eine Funktionsmischung von Wohnen, Arbeiten, in die Schule gehen, Einkaufen und Erholen, in räumlicher Nähe und maßvoller Dichte zu erreichen“, erläuterte Gernot Stöglehner vom Institut für Raumplanung, Umweltplanung und Bodenordnung an der BOKU. „Damit wäre nicht nur ein Beitrag zum Klimaschutz geleistet. Landwirtschaftliche Flächen und Lebensräume für Tiere und Pflanzen würden vor Bebauung geschützt und innerhalb der Zonen könnte eine hohe Lebensqualität gewährleistet werden.“ Da derzeit viele räumliche Entwicklungen in die Gegenrichtung laufen, ist ein rasches Umdenken notwendig.
Kooperation ist der Schlüssel zum Erfolg
Keine Landnutzung prägt die Erde und ihre Landschaften so stark wie die landwirtschaftliche Nutzung. Gleichzeitig wirken diese Landschaften stark auf den Menschen. Annette Piorr vom Leibniz Zentrum für Agrarlandschaftsforschung (Müncheberg, Deutschland) zeigt, dass der Bezug zur Landschaft, der zum Beispiel über ein Produkt oder dessen Vermarktung hergestellt werden kann, ganz maßgeblich zur Aufwertung dieses Produkts, bzw. zur Inwertsetzung der Landschaft beitragen kann. Anhand von Forschungsergebnissen aus europäischen Projekte diskutierte Dr. Piorr die Rolle von Innovation, Kooperation, Wissen und Zivilgesellschaft als Treiber von Landnutzung. „Beispiele aus der Praxis zeigen, dass regionale Ansätze und Lösungen die Landschaftsaufwertung begünstigen. Insbesondere Kooperationen sind dabei ein wichtiger Faktor.“
Optimierung durch Digitalisierung
Vor dem Hintergrund begrenzter Ressourcen, dem steigenden Bedarf an Nahrungsmitteln und den Wirkungen und Ursachen des Klimawandels ist die Steigerung der Ressourceneffizienz das Zukunftsthema in der Landwirtschaft. „Digitale Technologien wie z.B. sensorgestützte Düngung, oder Precision Farming können dazu beitragen, die Ressourceneffizienz zu steigern und die Umwelt zu entlasten“, betonte Kurt Jürgen Hülsbergen vom Institut für Ökologischen Landbau und Pflanzenbausysteme an der TU München. „Einzelmaßnahmen alleine können die Welt aber nicht verbessen, sie müssen in einem System eingebettet sein“. Hülsbergen gehört zu jenen Forschern, die Landnutzung nicht nur analysieren und bewerten, sondern auch aktiv in die landwirtschaftliche Praxis einbringen wollen. „Wir entwickeln derzeit in einem großen Forschungsverbund ein webbasiertes Managementsystem, das die agrarischen Wertschöpfungsketten optimieren.“ Dieses digitale Tool soll in Zukunft Bauern und Landwirten zur Verfügung stehen.
Auswirkungen globaler Veränderungen regional aufzeigen
Über integrative Landnutzungsmodellierung können Auswirkungen globaler Veränderungen auf die landwirtschaftliche Produktion und die Ernährungssicherung aufgezeigt, und effiziente Anpassungsmaßnahmen und -strategien im Vorfeld erkannt werden. Hermine Mitter vom Institut für nachhaltige Wirtschaftsentwicklung an der BOKU führte aus: „Modellergebnisse für Österreich demonstrieren, dass die Pflanzenerträge unter Annahme eines moderaten Klimawandel-Szenarios bis zur Mitte des 21. Jahrhunderts und bei ausreichender Wasserverfügbarkeit im nationalen Durchschnitt steigen.“ Allerdings variieren die Ergebnisse für unterschiedliche Pflanzen und Standorte sehr stark. „Zunehmende Extremwetterereignisse, neue Krankheiten und Schädlinge sowie Bodendegradation können die durchschnittlichen Erträge auch stark reduzieren. Mit Anpassungsmaßnahmen wie z. B. verdunstungsschonender Bodenbearbeitung und Fruchtfolge können Landwirte jedoch Risiken reduzieren und die neuen Chancen nutzen.“.
Lösungen sind vorhanden, aber komplex
Die Herbsttagung zeigte, dass das Thema der Landnutzung sehr komplex ist. Es bestehen vielfältige Herausforderungen und massive Wechselwirkungen, die nach systemaren Lösungsansätzen verlangen. „Es zeigt sich auch, dass vor allem auf regionaler Ebene vielversprechende Lösungsansätze bereitstehen,“ betont Jochen Kantelhardt betont abschließend. „Die Herausforderungen vor der die aktuelle Landnutzung steht, werden nicht von Einzelnen gelöst werden können. Forschung muss hier einen wichtigen Beitrag leisten und darauf achten, die Ergebnisse in die Regionen zu kommunizieren“.
Die Tagung fand am Freitag, den 15. November 2019 im Adolf von Guttenberghaus der Universität für Bodenkultur Wien statt.
Das Programm zur Tagung finden Sie hier.
Vorträge:
Begrüßung und Eröffnung: Jochen Kantelhardt, Leiter des BOKU-CAS
Sicherstellung der Welternährung im Jahr 2050: Essgewohnheiten, Bioenergie, agrarische Technologie und Treibhausgas-Emissionen
Ao. Univ. Prof. Mag. Dr. Helmut Haberl, Institut für Soziale Ökologie, BOKU Wien (Video)
Räumliche Entwicklungsdynamiken und Landnutzung: Betrachtungen aus raumplanerischer Perspektive
Univ. Prof. Dr. Gernot Stöglehner, Insitut für Raumplanung und Bodenordnung, BOKU Wien (Video)
Inwertsetzung von Landschaften durch Landwirtschaft: Konzepte, Strategien und Beispiele
Dr. Annette Piorr, Leibnitz Zentrum für Agrarlandschaftsforschung e.V., Müncheberg, Deutschland (Video)
Strategien zur Verbesserung der Ressourceneffizienz und Minderung von Treibhausgasflüssen in ökologischen konventionellen Landbausystemen
Prof. Dr. Kurt-Jürgen Hülsbergen, Lehrstuhl für ökologischen Landbau, Technische Universität München, Deutschland (Video)
Integrative Landnutzungsmodellierung: Auswirkungen globaler Veränderungen regional aufzeigen
Dipl. Ing. Dr. Hermine Mitter, Insitut für nachhaltige Wirtschaftsentwicklung, BOKU Wien (Video)
8. BOKU-CAS Herbsttagung: 120 Jahre Pflanzenschutz an der BOKU: Zwischen Wünschen, Visionen und Notwendigkeiten
-
 73 Bilder
73 Bilder(C) Siegrid Steinkellner -
 73 Bilder
73 BilderBOKU- Christoph Gruber -
 73 Bilder
73 BilderBOKU- Christoph Gruber -
 73 Bilder
73 BilderBOKU- Christoph Gruber -
 73 Bilder
73 BilderBOKU- Christoph Gruber -
 73 Bilder
73 BilderBOKU- Christoph Gruber -
 73 Bilder
73 BilderBOKU- Christoph Gruber -
 73 Bilder
73 BilderBOKU- Christoph Gruber -
 73 Bilder
73 BilderBOKU- Christoph Gruber -
 73 Bilder
73 BilderBOKU- Christoph Gruber -
 73 Bilder
73 BilderBOKU- Christoph Gruber -
 73 Bilder
73 BilderBOKU- Christoph Gruber -
 73 Bilder
73 BilderBOKU- Christoph Gruber -
 73 Bilder
73 BilderBOKU- Christoph Gruber -
 73 Bilder
73 BilderBOKU- Christoph Gruber -
 73 Bilder
73 BilderBOKU- Christoph Gruber -
 73 Bilder
73 BilderBOKU- Christoph Gruber -
 73 Bilder
73 BilderBOKU- Christoph Gruber -
 73 Bilder
73 BilderBOKU- Christoph Gruber -
 73 Bilder
73 BilderBOKU- Christoph Gruber -
 73 Bilder
73 BilderBOKU- Christoph Gruber -
 73 Bilder
73 BilderBOKU- Christoph Gruber -
 73 Bilder
73 BilderBOKU- Christoph Gruber -
 73 Bilder
73 BilderBOKU- Christoph Gruber -
 73 Bilder
73 BilderBOKU- Christoph Gruber -
 73 Bilder
73 BilderBOKU- Christoph Gruber -
 73 Bilder
73 BilderBOKU- Christoph Gruber -
 73 Bilder
73 BilderBOKU- Christoph Gruber -
 73 Bilder
73 BilderBOKU- Christoph Gruber -
 73 Bilder
73 BilderBOKU- Christoph Gruber -
 73 Bilder
73 BilderBOKU- Christoph Gruber -
 73 Bilder
73 BilderBOKU- Christoph Gruber -
 73 Bilder
73 BilderBOKU- Christoph Gruber -
 73 Bilder
73 BilderBOKU- Christoph Gruber -
 73 Bilder
73 BilderBOKU- Christoph Gruber -
 73 Bilder
73 BilderBOKU- Christoph Gruber -
 73 Bilder
73 BilderBOKU- Christoph Gruber -
 73 Bilder
73 BilderBOKU- Christoph Gruber -
 73 Bilder
73 BilderBOKU- Christoph Gruber -
 73 Bilder
73 BilderBOKU- Christoph Gruber -
 73 Bilder
73 BilderBOKU- Christoph Gruber -
 73 Bilder
73 BilderBOKU- Christoph Gruber -
 73 Bilder
73 BilderBOKU- Christoph Gruber -
 73 Bilder
73 BilderBOKU- Christoph Gruber -
 73 Bilder
73 BilderBOKU- Christoph Gruber -
 73 Bilder
73 BilderBOKU- Christoph Gruber -
 73 Bilder
73 BilderBOKU- Christoph Gruber -
 73 Bilder
73 BilderBOKU- Christoph Gruber -
 73 Bilder
73 BilderBOKU- Christoph Gruber -
 73 Bilder
73 BilderBOKU- Christoph Gruber -
 73 Bilder
73 BilderBOKU- Christoph Gruber -
 73 Bilder
73 BilderBOKU- Christoph Gruber -
 73 Bilder
73 BilderBOKU- Christoph Gruber -
 73 Bilder
73 BilderBOKU- Christoph Gruber -
73 Bilder
73 BilderBOKU- Christoph Gruber -
 73 Bilder
73 BilderBOKU- Christoph Gruber -
 73 Bilder
73 BilderBOKU- Christoph Gruber -
 73 Bilder
73 BilderBOKU- Christoph Gruber -
 73 Bilder
73 BilderBOKU- Christoph Gruber -
73 Bilder
73 BilderBOKU- Christoph Gruber -
 73 Bilder
73 BilderBOKU- Christoph Gruber -
 73 Bilder
73 BilderBOKU- Christoph Gruber -
 73 Bilder
73 BilderBOKU- Christoph Gruber -
 73 Bilder
73 BilderBOKU- Christoph Gruber -
 73 Bilder
73 BilderBOKU- Christoph Gruber -
 73 Bilder
73 BilderBOKU- Christoph Gruber -
 73 Bilder
73 BilderBOKU- Christoph Gruber -
 73 Bilder
73 BilderBOKU- Christoph Gruber -
 73 Bilder
73 BilderBOKU- Christoph Gruber -
 73 Bilder
73 BilderBOKU- Christoph Gruber -
 73 Bilder
73 BilderBOKU- Christoph Gruber -
 73 Bilder
73 BilderBOKU- Christoph Gruber -
 73 Bilder
73 BilderBOKU- Christoph Gruber
Die Gesunderhaltung von Kulturpflanzenbeständen stellt eine gesamtgesellschaftliche Herausforderung dar. Die qualitative und quantitative Sicherung pflanzlicher Rohstoffe für die menschliche Ernährung, für die Fütterung und für die industrielle Weiterverarbeitung erfordern zudem die Integration von Klima- und Umweltschutzüberlegungen. Das Zentrum für Agrarwissenschaften der Universität für Bodenkultur Wien und die BOKU Abteilung Pflanzenschutz haben der 8. BOKU CAS Herbsttagung den Titel "120 Jahre Pflanzenschutz an der BOKU: Zwischen Wünschen, Visionen und Notwendigkeiten" gegeben. Auf der Tagung wurden die Entwicklung und Bedeutung des Pflanzenschutzes anhand aktueller Themen aufgezeigt, zudem wurde ein breiter Überblick über die aktuelle Pflanzenschutzforschung an der BOKU gegeben: Eröffnet wurde die Veranstaltung durch Jochen Kantelhardt, Leiter des BOKU CAS, sowie Sabine Baumgartner, BOKU Vizerektorin für Lehre und Weiterbildung. Im ersten Vortrag gab Siegrid Steinkellner, Leiterin der BOKU Abteilung Pflanzenschutz, einen historischen Überblick über die Pflanzenschutzfoschung an der BOKU. Adolf Marksteiner, in Vertretung von Ferdinand Lembacher von der Landwirtschaftskammer Österreich, widmete sich dann dem Thema des Pflanzenschutzes in der österreichischen Landwirtschaft. Karl Crailsheim von der Karl-Franzens-Universität in Graz stellte das Projekt „Zukunft Biene" vor und besprach dabei insbesondere die Ursachen der Bienenverluste in Österreich. Sylvia Blümel von der AGES berichtete über invasive Arten, Andreas von Tiedemann von der Universität Göttingen ging in seinem Vortrag auf die Herausforderungen für den Pflanzenschutz in der Zukunft ein. Abgeschlossen wurde der Vortragsteil der Tagung mit einem Einblick in aktuelle Arbeiten und Projekte der BOKU Abteilung Pflanzenschutz. Im Anschluss an die Tagung hatten die TeilnehmerInnen die Möglichkeit, Führungen durch den Standort des UFT, durch die Gewächshäuser und Labors wahrzunehmen. Begleitet wurde die Tagung darüber hinaus von einer beeindruckenden Posterausstellung über aktuelle BOKU Forschungsarbeiten zum Thema. Die Tagung fand am Donnerstag, den 15. November 2018 am BOKU Universitäts- und Forschungszentrum, Konrad-Lorenzstraße 24, in 3430 Tulln statt. Das Programm zur Tagung finden Sie hier. Vorträge: Eröffnung: Jochen Kantelhardt, Leiter des BOKU-CAS (Video)
Begrüßung: Sabine Baumgartner, BOKU Vizerektorin für Lehre und Weiterbildung (Video) 120 Jahre Pflanzenschutz an der BOKU: Pflanzenschutz in Lehre und Forschung: Siegrid Steinkellner, Leiterin der BOKU Abteilung Pflanzenschutz am UFT (Video)
Pflanzenschutz in der österreichischen Landwirtschaft: Ökologie und Ökonomie im Einklang ist die Zielsetzung: Adolf Marksteiner, Landwirtschaftskammer Österreich (Video)
Pflanzenschutz – Herausforderungen für die Zukunft: Andreas von Tiedemann, Georg-August-Universität Göttingen (Video) Zukunft Biene - Über die Ursachen der Bienenverluste in Österreich: Karl Crailsheim, Karl-Franzens-Universität Graz (Video)
Phytosanitäre Schaderreger - immer aktuell: Herausforderungen und Perspekiven: Sylvia Blümel, AGES und BOKU Wien Im Fokus: Ein Themenquerschnitt aus der Abteilung Pflanzenschutz: Elisabeth Koschier, Markus Redl, Krzysztof Wieczorek, Theresa Steiner und Karin Hage-Ahmed, Abteilung Pflanzenschutz, BOKU Wien (Video) Videoplaylist aller Vorträge Pressestimmen: Niederösterreichische Nachrichten
7. CAS Herbsttagung "Spannungsfeld tierische Produktion: vielfältige Ansprüche verlangen einen systemischen Ansatz"
-
 49 Bilder
49 Bilder -
 49 Bilder
49 Bilder -
 49 Bilder
49 BilderFoto: BOKU -
 49 Bilder
49 BilderFoto: BOKU -
 49 Bilder
49 BilderFoto: BOKU -
 49 Bilder
49 BilderFoto: BOKU -
 49 Bilder
49 BilderFoto: BOKU -
 49 Bilder
49 BilderFoto: BOKU -
 49 Bilder
49 BilderFoto: BOKU -
 49 Bilder
49 BilderFoto: BOKU -
 49 Bilder
49 BilderFoto: BOKU -
 49 Bilder
49 BilderFoto: BOKU -
 49 Bilder
49 BilderFoto: BOKU -
 49 Bilder
49 BilderFoto: BOKU -
 49 Bilder
49 BilderFoto: BOKU -
 49 Bilder
49 BilderFoto: BOKU -
 49 Bilder
49 BilderFoto: BOKU -
 49 Bilder
49 BilderFoto: BOKU -
 49 Bilder
49 BilderFoto: BOKU -
 49 Bilder
49 BilderFoto: BOKU -
 49 Bilder
49 BilderFoto: BOKU -
 49 Bilder
49 BilderFoto: BOKU -
 49 Bilder
49 BilderFoto: BOKU -
 49 Bilder
49 BilderFoto: BOKU -
 49 Bilder
49 BilderFoto: BOKU -
 49 Bilder
49 BilderFoto: BOKU -
 49 Bilder
49 BilderFoto: BOKU -
 49 Bilder
49 BilderFoto: BOKU -
 49 Bilder
49 BilderFoto: BOKU -
 49 Bilder
49 BilderFoto: BOKU -
 49 Bilder
49 BilderFoto: BOKU -
 49 Bilder
49 BilderFoto: BOKU -
 49 Bilder
49 BilderFoto: BOKU -
 49 Bilder
49 BilderFoto: BOKU -
 49 Bilder
49 BilderFoto: BOKU -
 49 Bilder
49 BilderFoto: BOKU -
 49 Bilder
49 BilderFoto: BOKU -
 49 Bilder
49 BilderFoto: BOKU -
 49 Bilder
49 BilderFoto: BOKU -
 49 Bilder
49 BilderFoto: BOKU -
 49 Bilder
49 BilderFoto: BOKU -
 49 Bilder
49 BilderFoto: BOKU -
 49 Bilder
49 BilderFoto: BOKU -
 49 Bilder
49 BilderFoto: BOKU -
 49 Bilder
49 BilderFoto: BOKU -
 49 Bilder
49 BilderFoto: BOKU -
 49 Bilder
49 BilderFoto: BOKU -
 49 Bilder
49 BilderFoto: BOKU -
 49 Bilder
49 BilderFoto: BOKU
7. BOKU-CAS Herbsttagung: "Spannungsfeld tierische Produktion: vielfältige Ansprüche verlangen einen systemischen Ansatz" Moderne, hoch produktive tierische Produktionssysteme müssen vielfältige Ansprüche und Anforderungen erfüllen, die häufig konkurrieren. Die 7. BOKU-CAS Herbsttagung widmete sich der tierischen Produktion und dabei insbesondere dem Spannungsfeld zwischen den Ansprüchen der Gesellschaft, der Bäuerinnen und Bauern, der Konsumentinnen und Konsumenten, der Tiere, aber auch der Umwelt. Auf der Tagung wurden aktuelle Fragestellungen zu den Themen Tierwohl und gesellschaftliche Ansprüche, moderne Technologien in der Tierzucht sowie Ressourcenschonung und Ernährungssicherung beleuchtet. Die Tagung fand am Montag, 27. November 2017 im Wilhelm-Exner-Haus der Universität für Bodenkultur, Wien statt. Das Programm zur Tagung finden Sie hier. Vorträge: "Moderne Technologien zur Umsetzung von Zuchtzielen" (Video)
Univ.Prof. Dr. Johann Sölkner, Leiter, Institut für Nutztierwissenschaften, BOKU "Schlachtung trächtiger Tiere: Ein wenig beachtetes Problem" (Video)
Univ.Prof. Dr. Christoph Winckler, stellv. Leiter Institut für Nutztierwissenschaften, BOKU "Klimafreundliche und ressourceneffiziente Ernährung der Wiederkäuer - Einblick und Ausblick" (Video)
Dr. Angela Schwarm, Bereichsleiterin, Verdauung, Stoffwechsel und Umwelt, ETH Zürich "Technologische Futteraufbereitung als Beitrag zur Ressourcenschonung" (Video)
Univ.Prof. Dr. Martin Gierus, Leiter, Institut für Tierernährung, Tierische Lebensmittel und Ernährungsphysiologie, BOKU "Tierische Produktion - Beitrag zur oder Gefahr für die Ernährungssicherung?" (Video)
Ao.Univ.Prof. Dr. Werner Zollitsch, Leiter, Department für Nachhaltige Agrarsysteme, BOKU Videoplaylist aller Vorträge
6. CAS Herbsttagung "Körnerleguminosen - wertvolle Körner für eine nachhaltige Landwirtschaft"
-
 20 Bilder
20 BilderFotos: J.Vollmann -
 20 Bilder
20 BilderFoto: J. Snajdr -
 20 Bilder
20 BilderFoto: J. Snajdr -
 20 Bilder
20 BilderFoto: J. Snajdr -
 20 Bilder
20 BilderFoto: J. Snajdr -
 20 Bilder
20 BilderFoto: J. Snajdr -
 20 Bilder
20 BilderFoto: J. Snajdr -
 20 Bilder
20 BilderFoto: J. Snajdr -
 20 Bilder
20 BilderFoto: J. Snajdr -
 20 Bilder
20 BilderFoto: J. Snajdr -
 20 Bilder
20 BilderFoto: J. Snajdr -
 20 Bilder
20 BilderFoto: J. Snajdr -
 20 Bilder
20 BilderFoto: J. Snajdr -
 20 Bilder
20 BilderFoto: J. Snajdr -
 20 Bilder
20 BilderFoto: J. Snajdr -
 20 Bilder
20 BilderFoto: J. Snajdr -
 20 Bilder
20 BilderFoto: J. Snajdr -
 20 Bilder
20 BilderFoto: J. Snajdr -
 20 Bilder
20 BilderFoto: J. Snajdr -
 20 Bilder
20 BilderFoto: J. Snajdr
Anlässlich des 'UN International Year of Pulses 2016' widmete sich die 6. Herbsttagung des BOKU Zentrums für Agrarwissenschaften dem Thema Körnerleguminosen. Beleuchtet wurden aktuelle Fragestellungen aus Pflanzenzüchtung und Pflanzenbau, Möglichkeiten der Vermarktung, der industriellen Verwertung in der Tierernährung und der Verwendung als Lebensmittel, sowie die Frage der Nachhaltigkeit einer GVO-freien Eiweißversorgung. Am Nachmittag bestand die Möglichkeit, die Forschungseinrichtungen am BOKU Standort Tulln zu besichtigen. Die Führungen gaben Einblick in die Forschungslabors der Abteilungen Pflanzenzüchtung, Pflanzenschutz und Pflanzenbau des Departments für Nutzpflanzenwissenschaften. Es wurden vielfältige Arbeiten vorgestellt, die sich mit Körnerleguminosen und anderen wichtigen Nutzpflanzenarten für die Versorgung von Mensch und Tier mit Nahrung, Futtermitteln und nachwachsenden Industrierohstoffen beschäftigen. Das Programm zur Tagung finden Sie hier! Die Videos der Vorträge können Sie in der richtigen Reihenfolge über unsere Playlist abrufen, oder aber über die untenstehenden links.
- Begrüßung und Eröffnung - Univ. Prof. Dr. Jochen Kantelhardt, Leiter des BOKU-CAS
- „Agrarwissenschaften am Standort Tulln“ Teil 1 - Univ. Prof. Dipl.-Ing. Dr. Hans-Peter Kaul
- "Agrarwissenschaften am Standort Tulln" Teil 2 Univ. Prof. Dipl.-Ing. Dr. Hermann Bürstmayr
- "Sojabohnenzüchtung für Futter- und Nahrungsmittelproduktion" - Ao. Univ. Prof. Dr. Johann Vollmann
- "Donau Soja für eine nachhaltige europäische Eiweißversorgung" - Mag. Ursula Bittner
- “Winterkörnerleguminosen als Produktionsalternativen” - Priv.-Doz. Dr. Reinhard Neugschwandtner
- "Eigenschaften und Prozessierung von Körnerleguminosen für die Human- und Tierernährung” - Priv.-Doz. Dr. Karl Schedle & Univ. Prof. Dr. Ing. Henry Jäger
- “Ökonomische Betrachtung von Nachhaltigkeitsfragen einer GVO-freien Eiweißversorgung unter Berücksichtigung neuer Entwicklungen in der Pflanzenzüchtung” - Prof. Dr. Justus Wesseler
5. CAS Herbsttagung: Boden und Landwirtschaft - Ökonomie, Ökologie und soziale Ansprüche
-
 40 Bilder
40 BilderFoto: BOKU -
 40 Bilder
40 BilderFoto: BOKU -
 40 Bilder
40 BilderFoto: BOKU -
 40 Bilder
40 BilderFoto: BOKU -
 40 Bilder
40 BilderFoto: BOKU -
 40 Bilder
40 BilderFoto: BOKU -
 40 Bilder
40 BilderFoto: BOKU -
 40 Bilder
40 BilderFoto: BOKU -
 40 Bilder
40 BilderFoto: BOKU -
 40 Bilder
40 BilderFoto: BOKU -
 40 Bilder
40 BilderFoto: BOKU -
 40 Bilder
40 BilderFoto: BOKU -
 40 Bilder
40 BilderFoto: BOKU -
 40 Bilder
40 BilderFoto: BOKU -
 40 Bilder
40 BilderFoto: BOKU -
 40 Bilder
40 BilderFoto: BOKU -
 40 Bilder
40 BilderFoto: BOKU -
 40 Bilder
40 BilderFoto: BOKU -
 40 Bilder
40 BilderFoto: BOKU -
 40 Bilder
40 BilderFoto: BOKU -
 40 Bilder
40 BilderFoto: BOKU -
 40 Bilder
40 BilderFoto: BOKU -
 40 Bilder
40 BilderFoto: BOKU -
 40 Bilder
40 BilderFoto: BOKU -
 40 Bilder
40 BilderFoto: BOKU -
 40 Bilder
40 BilderFoto: BOKU -
 40 Bilder
40 BilderFoto: BOKU -
 40 Bilder
40 BilderFoto: BOKU -
 40 Bilder
40 BilderFoto: BOKU -
 40 Bilder
40 BilderFoto: BOKU -
 40 Bilder
40 BilderFoto: BOKU -
 40 Bilder
40 BilderFoto: BOKU -
 40 Bilder
40 BilderFoto: BOKU -
 40 Bilder
40 BilderFoto: BOKU -
 40 Bilder
40 BilderFoto: BOKU -
 40 Bilder
40 BilderFoto: BOKU -
 40 Bilder
40 BilderFoto: BOKU -
 40 Bilder
40 BilderFoto: BOKU -
 40 Bilder
40 BilderFoto: BOKU -
 40 Bilder
40 BilderFoto: BOKU
Die 5. CAS-Herbsttagung des BOKU Zentrums für Agrarwissenschaften beschäftigte sich mit dem Thema der landwirtschaftlichen Bodenbewirtschaftung im Spannungsfeld ökonomischer, ökologischer und sozialer Ansprüche. Die Vorträge nationaler und internationaler ReferentInnen spannten einen Bogen, der von aktuellen Fragestellungen in der österreichischen Bodenforschung über die Auswirkungen des weltweit steigenden Bedarfs an Nahrungsmitteln und nachwachsenden Rohstoffen auf die landwirtschaftliche Bodennutzung bis hin zu den Auswirkungen agrarpolitischer Entscheidungen auf die Boden- und Pachtpreise reicht.
Nach der Tagung fand eine Führung durch die Bodenlabore des BOKU Instituts für Bodenforschung statt. Hier wurden aktuelle Forschungsarbeiten im Bereich der Spurengasmessungen (Bodenatmung, Biomasse, klimarelevante Gase), der Bodenstruktur (vom Bodenpartikel zum Aggregat, Aggregatstabilität, Minimalbodenbearbeitung) und der Rückstandsanalytik (Glyphosat in Boden und Sickerwasser) vorgestellt und deren Bedeutung für die landwirtschaftliche Praxis diskutiert.
Videos der Vorträge:
Begrüßung und Eröffnung
Univ. Prof. Dr. Jochen Kantelhardt, Leiter des BOKU-CAS
„Boden an der Bodenkultur“
Univ. Prof. Dr. Martin Gerzabek, Rektor der Universität für Bodenkultur
„Biofuels' Unbalanced Equations: Theoretical Demand,
Misleading Statistics, and Measured Soil Capabilities“
Dr. Kate Showers, Centre for World Environmental History, University of Sussex and Five Colleges, Amherst, Massachusetts, USA
„The Impact of agricultural policy on land sales and rental prices“
Univ. Prof. Mag. Dr. Klaus Salhofer Institut für Nachhaltige Wirtschaftsentwicklung, BOKU
4. CAS Herbsttagung: Bioökonomie - ein Schwerpunkt in der BOKU Forschung
21. November 2014 Zukunftsfähigkeit der Bioökonomie aus globaler Sicht Schritte zur Entwicklung einer österreichischen Bioökonomie-Strategie Beiträge der Naturwissenschaften, der Ökonomie und der Energietechnik zum Thema Grenzen der Bioökonomie Programm 4. CAS-Herbsttagung 2014 BOKU youtube Die Vorträge der Herbsttagung finden Sie unter den 'uploads'!
3. CAS Herbsttagung: Markt oder Staat - Perspektiven für die Landwirtschaft
22. November 2013
"Globale Ressourcenverfügbarkeit und die Rolle von Weltagrarmärkten"
Univ.Prof.Dr. Harald von Witzke, Internationaler Agrarhandel und Entwicklung, Humboldt-Universität zu Berlin
"Landwirtschaft ohne Subventionen? Marktliberale Konzepte und ihre praktische Relevanz"
Univ.Prof.Dr. Markus Hofreither, Inst. f. Nachhaltige Wirtschaftsentwicklung, BOKU "Naturnahe Landschaftselemente im Agrarland - wie wichtig sind sie für die Biodiversität?"
Univ.Prof.Dr. Thomas Frank, Inst. f. Zoologie, BOKU "Resilienz und der Umgang mit dynamischen Rahmenbedingungen - die Sicht der Betriebe"
Assoc.Prof.Dr. Ika Darnhofer, Inst. f. Agrar- und Forstökonomie, BOKU
2. CAS - Herbsttagung: Ecological and sustainable intensification
<h5>15. November 2012</h5> "Ist nachhaltige Landwirtschaft ohne technologischen Wandel möglich?
Ein geschichtlicher Rückblick"
Dr. Philipp Aerni - Prof. f. Agrarwirtschaft, ETH Zürich,
Senior Researcher, World Trade Institute, Univ. Bern, derzeit FAO, Rom "Nachhaltige Ressourcennutzung in der Landwirtschaft - Was kann die Pflanzenzüchtung dazu beitragen?"
Univ.Prof.Dr. Hermann Bürstmayr, Inst. f. Biotechnologie i. d. Pflanzenproduktion "Bodenressourcen, Bodenfunktionen und nachhaltige Entwicklung"
Univ.Prof.Dr. Martin Gerzabek - Inst. f. Bodenforschung, Dep. f. Wald- und Bodenwissenschaften
Rektor der BOKU "Ecological intensification tierischer Produktionssysteme - Optionen aus österreichischer Perspektive"
Ao. Univ.Prof.Dr. Werner Zollitsch - Inst. f. Nutztierwissenschaften, Dep. f. Nachhaltige Agrarsysteme
Univ. Prof.Dr. Jochen Kantelhardt - Inst. f. Agrar- und Forstökonomie, Dep. f. Wirtschafts- und Sozialwissenschaften
1. CAS - Herbsttagung: Quo vadis Agrarwissenschaft?
<h5>14. November 2011 </h5> Agrarwissenschaftliche Forschung
"Forschung in den Agrar- und Forstwissenschaften -
Eine Positionsbestimmung aus Sicht der DFG"
Univ.Prof.Dr. Wolfgang Friedt (Univ. Gießen, DFG)" "Können sich die Agrarwissenschaften ihre Forschung selbst organisieren?"
Univ.Prof.Dr. Thomas Jungbluth (Univ.Hohenheim, DAFA) Erwartungen der Gesellschaft an die Agrarwissenschaften "Nachhaltig die Welt ernähren"
Dr. Franz Fischler (Ökosoziales Forum) Leitbild der Agrarwissenschaften an der BOKU Impulsreferate zum Thema:
Ao.Univ.Prof. DI.Dr. Herbert Weingartmann (BOKU-CAS)
Stephan Pabst, Bakk.techn. (bis 2011, Studienvertreter AW) Diskussion
"Was sollen und können die Agrarwissenschaften leisten?"
Moderator: Gen.Sekr. Mag.DI.Dr. Reinhard Mang
(Lebensministerium und Beirat des CAS)









